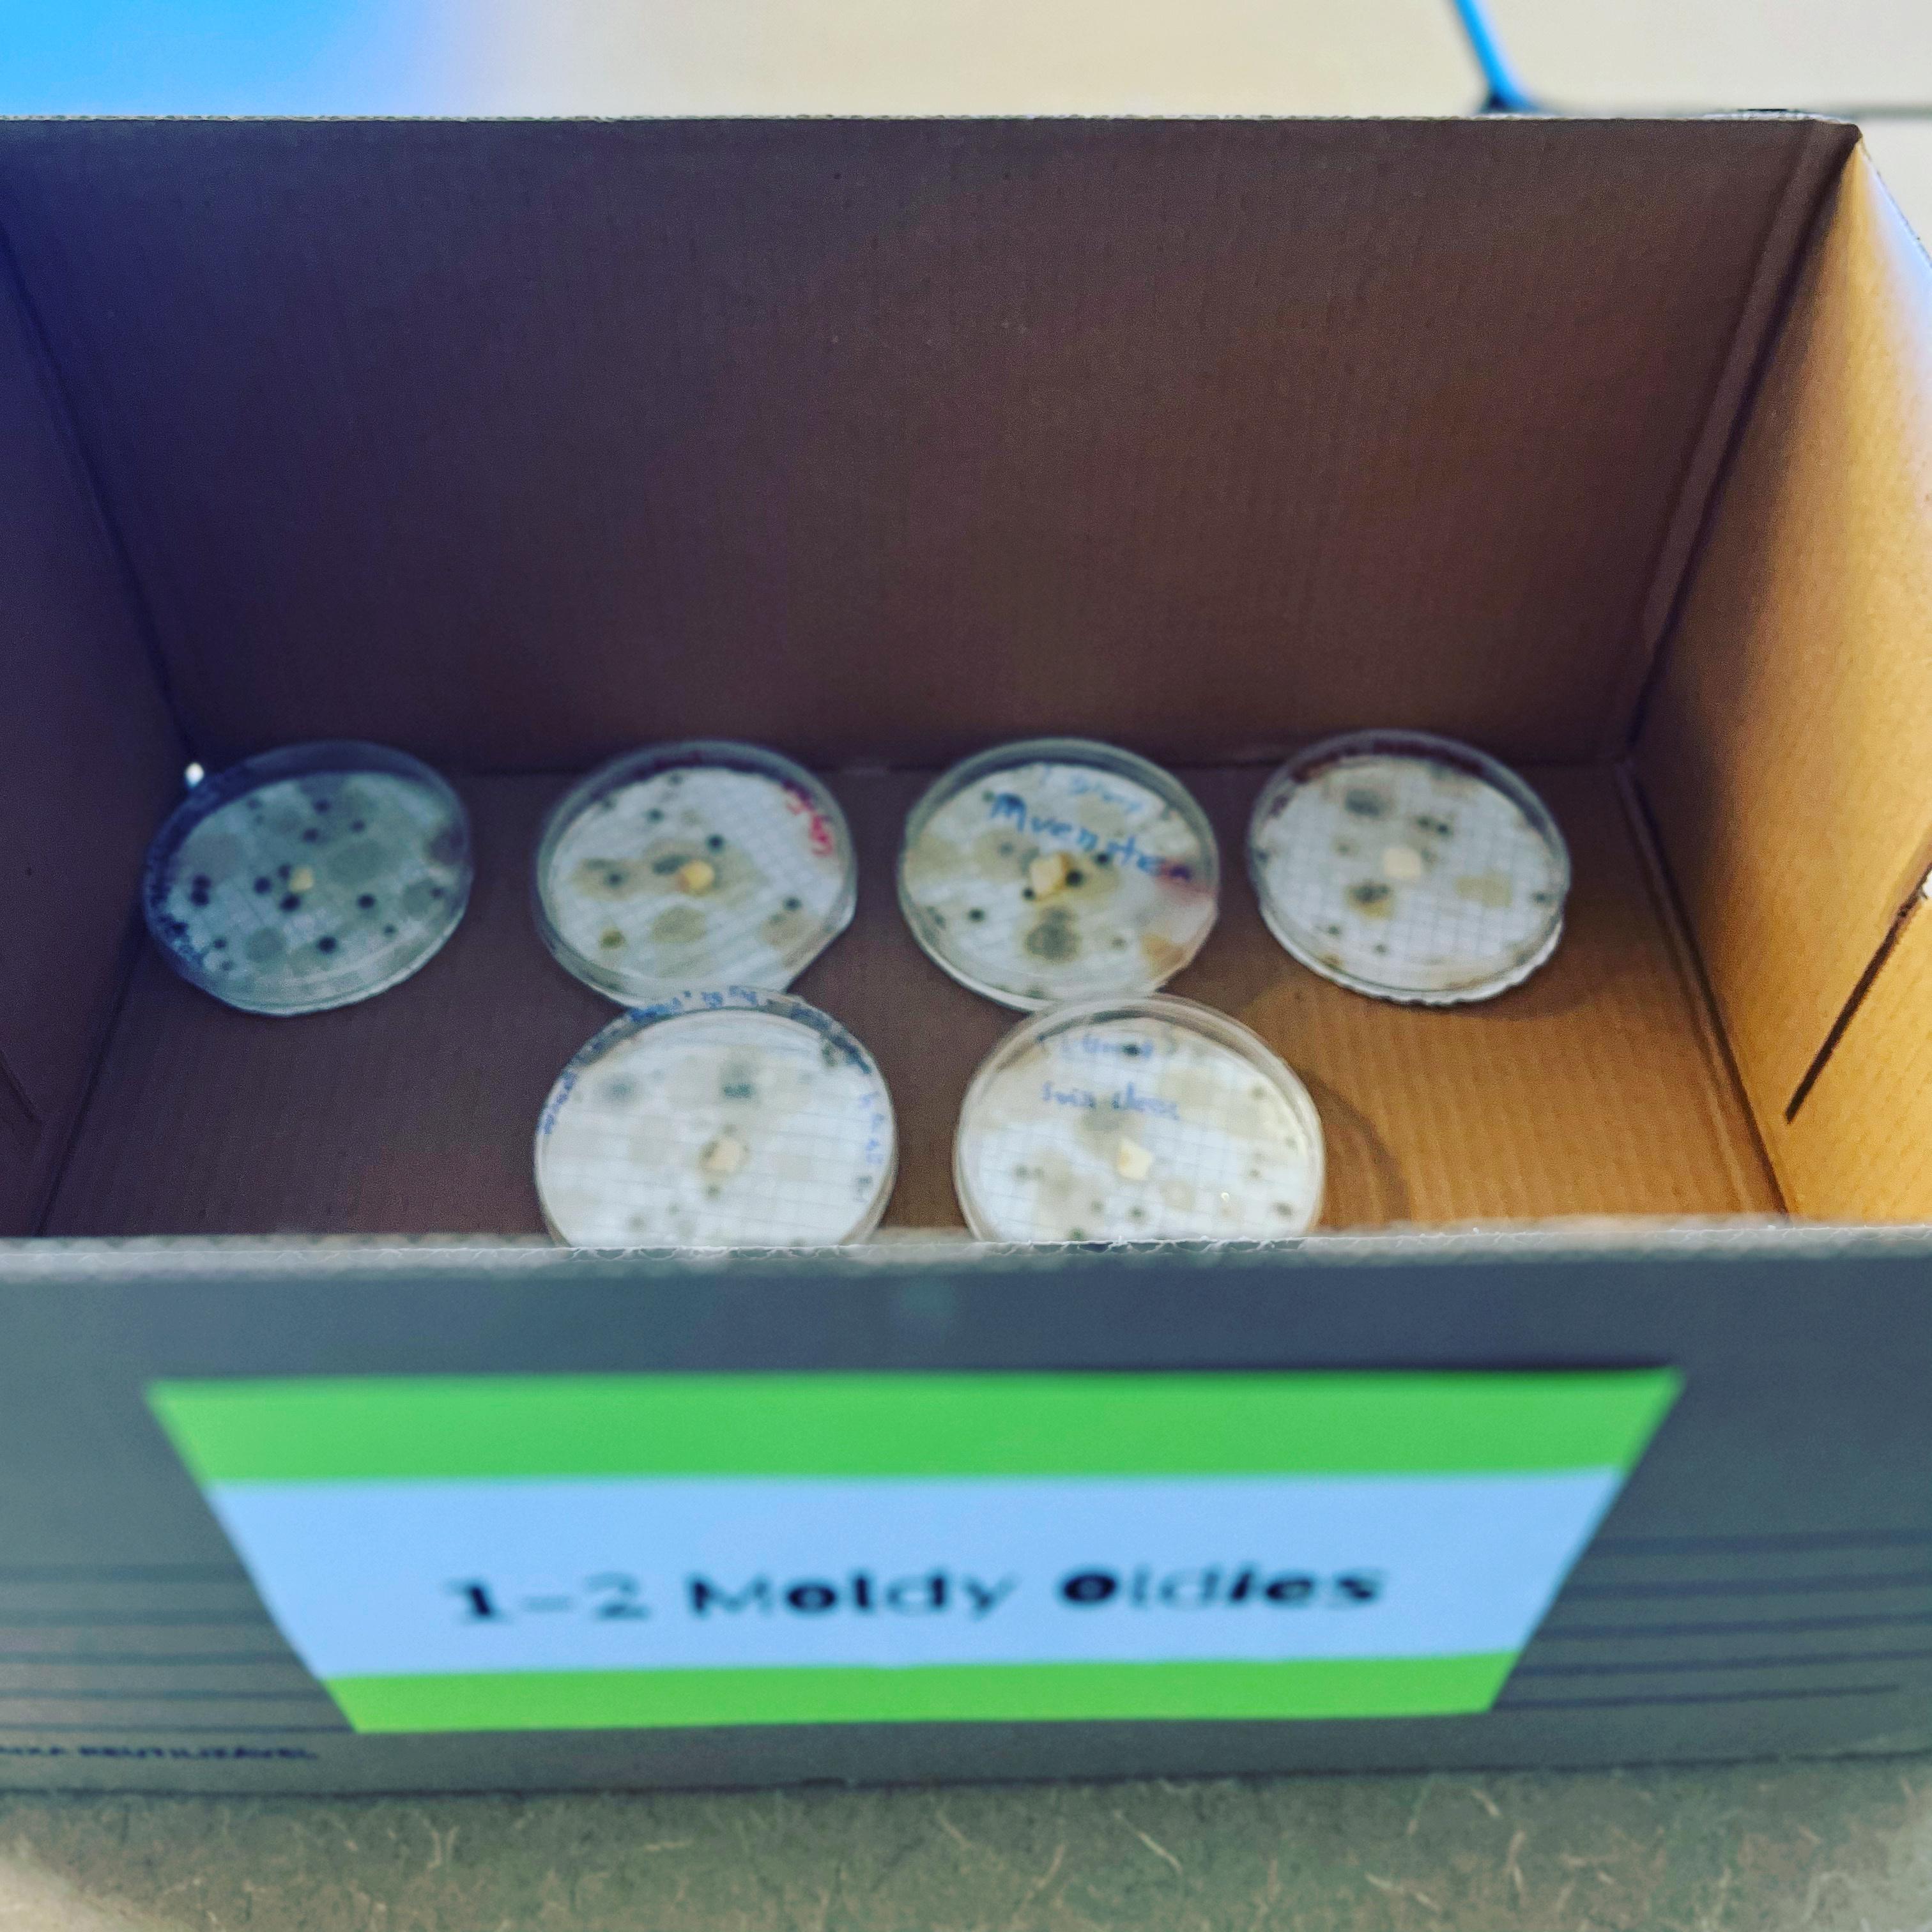

Lovejoy Community,
January is School Board Recognition Month and we are celebrating our Lovejoy ISD Board of Trustees for their dedication and commitment to our district and students. A strong, student-centered board is critical to the success of Lovejoy ISD and we are grateful for the countless hours each trustee spends in support of our students, staff, and district. Lovejoy ISD Trustees serve selflessly in an elected, volunteer leadership role. Trustees are elected for rotating three-year terms. Each of the

seven trustees represent the district as a whole, not a specific geographical area. The Board fulfills its responsibilities by providing strong leadership and governance.
The Lovejoy ISD Board of Trustees will be formally honored at the January 23 Board Meeting. Additionally, each Trustee is partnered with one of our schools for appreciation and a stakeholder connection opportunity. Throughout January, my weekly digital newsletter will feature photos and information that give you the opportunity to learn more about each of our dedicated trustees.
I am deeply grateful for the Board’s collaborative, student-centered approach to tackling challenges faced by our district as well as their focus on living our mission of propelling every person to personal excellence.
There is only ONE LOVEJOY and we are ALL LEOPARDS!
Katie Kordel Superintendent

Election or Appointment Month & Year: September 2019, May 2021
Professional and/or Volunteer Background:
Owner and Operator of Owens Warford Custom Homes
Owner and President of Capacity Lending, LLC Over 20 years in Real Estate Construction, Finance and Development as well as investment management
Past Member of the board of directors and the Chief Lending Officer for First National Bank of Trenton, now Cap Tex Bank Youth baseball and softball coach for his son Cooper and daughters Jade and Macy. He enjoys teaching kids the value of teamwork, sportsmanship, and the privilege of being able to participate in sports.
Member of Chase Oaks Church
Personal Highlights: My wife I and met my first year in college and we have 3 amazing children that have attended Lovejoy since Kindergarten.
Favorite Lovejoy Tradition: Homecoming
Your "WHY": My love for children and family combined with my belief in public education motivates me to use my time and experiences to serve our community and help build on our legacy of excellence at Lovejoy. I want to continue the development of “Living Lovejoy” and provide new opportunities in a place where every student is motivated to achieve their goals.
Contact Information: barrett owens@lovejoyisd.net


Election or Appointment Month & Year: May 2016, 2019 and 2022
Professional and/or Volunteer Background:
Certified Life, Growth, Health and Wellness CoachSmithCoaching com Senior Search Consultant with JG Consulting Director of Education Solutions Consultant at Enseo
Personal Highlights: My greatest joys are my husband, Abe, of 25 years, my 4 children and dog, Ace, and being on a tennis court
Favorite Lovejoy Tradition: Heart of the Teacher! I Love to celebrate and lift up our incredible and deserving staff.
Your "WHY": My "Why" to serve is to inject positivity, support and solutions to continue to preserve our uniquely special community and district
Contact Information: amyj smith@lovejoyisd.net

Election or Appointment Month & Year: May 2017, 2020
Professional and/or Volunteer Background:
10 years working in sales
PTA President of Lovejoy Elementary and Sloan Creek Intermediate 2 terms served on the Foundation for Lovejoy Schools, including serving as annual appeal chair
Over ten years on Lovejoy Council of PTAs/PTOs. Continues to serve on the LHS and Council boards
Active member of National Charity League of Allen, where I served as NCL Allen President 2020–2021
Personal Highlights: Married almost 23 years to my fabulous husband, Ryan. I have two Lovejoy high schoolers-Aidan (senior) and Madeline (junior). Love my two precious dogs-Molly Mae (morkie) and Luka (silver lab). I love sports, playing tennis, traveling. I really LOVE shoes:)
Favorite Lovejoy Tradition: Reading with the Leopards!
Your "WHY": I wanted to make a bigger impact after serving at the campus levels for PTA and on the Foundation.
Contact Information: anne smith@lovejoyisd.net

.
Sloan Creek Intermediate, Willow Springs Middle School, and Lovejoy High School will host 4th, 6th, and 8th graders on Friday, February 3, 2023, for Lovejoy ISD’s Annual Bump Up Day. Bump Up Day was created to assist students with transitioning to a new campus and to help generate excitement for the new experiences they will have. Students will travel to the campus they will be attending for the 20232024 school year and have the opportunity to tour the campus, ask questions, and eat lunch. Students will be able to charge lunch and any a la carte/snacks purchases to their lunch account during their visit to their Bump Up school. Please make sure funds are available in your student's lunch account. Lunch prices for students visiting Sloan Creek Intermediate School or Willow Springs Middle School will be $4.00 for a regular meal or $4.75 for a premium meal. Lunch prices for students visiting Lovejoy High School will be $4.50 for a regular meal or $5.25 for a premium meal. A la carte/snack prices vary. Please refer to this document for specific pricing.
WSMS art teacher, Laci Garza, and her students inadvertently started a new districtwide Lovejoy trend #ShareTheLovejoy through a class project! Students created clay hearts to represent the unique Lovejoy connection in our "One Heart, One Lovejoy" core value. Then these tiny clay tokens were shared at school, as well as the Fine Arts Festival.
If you have received one, let it be a reminder that your contribution matters, you are seen and valued. You can hold on to it as long as you need and then you can pass it on to #ShareTheLovejoy with someone else. You can #ShareTheLovejoy by snapping a picture and giving someone a shout out on social media, leaving it quietly with a note, or hiding for someone to find! The possibilities are endless.
There's no need to wait for a WSMS-made heart to participate. Hearts can be anything! They can be drawn on a sticky note, cut out with a fancy stencil or a simple pair of scissors, origami, painted on a rock, made from melted crayon, or whatever you can think of! They can be given to ANYONE!
Lets #ShareTheLovejoy as a celebration of everything that makes Lovejoy special!
Superintendent Kordel took the opportunity to #ShareTheLovejoy with her LHS Superintendent Connection Council at Thursday's meeting.

Lovejoy ISD would like to invite our Silver Leopard patrons to enjoy an evening of musical theatre. The LHS Performing Arts will be presenting The Addams Family: A New Musical on January 19 - 21, 2023 at 7pm. We are offering a limited number of special Silver Leopard VIP seating on our Opening Night, January 19th, 2023. This ticket includes meeting our LHS Musical faculty, Jessica Brewster, Kelly Martin and Jacklyn Simone during intermission. Dr. Fela Mathy, Director of Fine Arts will greet you at the theatre box office for seating and answer any questions about Lovejoy Fine Arts or our LHS musical. If you would like to attend Opening Night, please stop by the Lovejoy Administration Building to pick up your ticket in advance. The front receptionist will have tickets available while supplies last.
If you would like to attend the show on a different evening, other than Opening Night, you are welcome to review our available tickets online and purchase seats for any other performance available. The online box office can be found at www.lovejoyfinearts.org.






January 23 Student Calendar Link
Board of Trustees Meeting - LCDC Library
Closed Session @ 6:00PM in C113
Open Session is expected to begin at approximately 7:00PM

Board of Trustees Workshop - LCDC Library
Closed Session @ 8:30AM in C113
Open Session is expected to begin at approximately 9:00AM
Campus, District, and Athletics Calendars are linked above for the convenience of our community *Please note event dates, times and locations are subject to change and should be verified by participants.
WSMS Art 1 students channeled their inner Banksy and covered the windows of WSMS with squiggly lines that are the product of an art exercise called contour line.




Each drawing, made up of a single line from start to finish, grows students’ observation skills because it forces them to focus on what they actually see rather than what they think they ‘should’ see. The exercise effectively ‘switches off’ the rational left side of the brain and allows the more creative right side of the brain to take over. Additionally, it increases hand-eye coordination, calms the mind and creates new neural connections.
It can be mentally exhausting to maintain the level of focus required, so the windows canvas offered a novel surface and a different drawing position to keep their brains engaged.
The Algebra I team at Willow Springs is getting Moldy! Ashley Morgan, Jacob Hunter, and Rachael Kowalski collaborated to create an opportunity for students to experience the natural occurrence of exponential functions. The math classes started with the tiniest bits of cheese in a petri dish and now have impressive "moldy oldies" (all in a safely contained and sanitized environment of course)!"
The teachers are excited for their students to have a memorable experience as they connect a real, present and live situation to an incredibly common mathematical function. Not only will students observe the area covered by mold growth but they will research the causes, collect and plot their data, use exponential regression to write an equation and predict the growth on future days! They’ll also have the opportunity to compare their mathematical predictions with the actual results. Students are mastering many future-ready skills as they collaborate in teams to put their findings together in a presentation all while getting an answer to the never-ending math question: “Why do we need to learn this?”
Mrs. Morgan, Mrs. Kowalski and Mr. Hunter are confident they are among some future mathematical research scientists, statisticians, engineers, physicists and programmers - sitting in their classrooms right now!

This past weekend, the Lovejoy Band had a record 21 students advance to the area round of the Texas Music Educator Association (TMEA) All-State Process. The following 5 students have earned a spot in the All State Bands and will travel to San Antonio in February to perform with the best young musicians in the state.

We had MANY students one or two away from a spot which is heartbreaking, but they are amongst the best in the entire state and we are celebrating their playing as well! Go Band!!
Lauren Dumin, Flute Reagan Wagner, Trumpet
John Hanchey, Percussion Max Rattleff, Percussion Davis Miller, Jazz Baritone Saxophone


Lovejoy ISD is committed to providing consistent, transparent communication with our community and employees. We hope this meeting summary will support you in staying connected and informed.
Additionally, Regular Board Meetings and Workshops are now recorded and archived on the Lovejoy ISD website. You can access recordings by clicking the picture to the right. Passwords are noted below the recording links.


The Lovejoy Board of Trustees approved Mr. John Korb for the position of Director of Technology. We believe John will serve as an excellent fit for the position. He has experience serving as a classroom teacher, Region Service Center Coordinator, and District Director of Instructional Technology Services. These experiences bring to the position professional insight regarding technology infrastructure, network, equipment, and devices, as well as an understanding of the end
user experience in the classroom setting. Please join us in welcoming John to the Lovejoy team.
Reminder:
and
Due to a recent change in safety and security procedures, all Lovejoy ISD Board Meeting and/or Board Workshop attendees must enter through the main entry door of the Lovejoy Child Development Center (LCDC), which is located just west of the previous entry. Upon entrance, attendees will enter the boardroom from the LCDC lobby area. Note: Attendees should follow the directional signage that will be posted for upcoming meetings. Only those seeking public comment will be required to sign in, as according to board policy. In addition, the Lovejoy ISD Board Closed Session room has changed to room C113 in the Carrie L. Child Development Center.
These safety and security procedures will only enhance the quality of the Lovejoy ISD Board Meetings. Please contact Rodricka Taylor: rodricka taylor@lovejoyisd.net if you have any questions.

The following positions will be on the May 6, 2023 ballot:
Position 4: Anne Smith
Position 5: Marvin Bobo
Board of Trustee Application Packets are now available for pick-up from Rodricka Taylor, Coordinator for the Superintendent and Board Services, at the Red School House (259 Country Club Rd., Allen, TX 75002). An Electronic Application Packet can be downloaded HERE.
Upcoming Dates and Deadlines
Wednesday, January 18, 2023
First Day to File for a Place on the General Election Ballot
Friday, February 17, 2023
Last Day to Order a General Election
Friday, February 17, 2023 at 5:00 PM
Last Day to File for a Place on the General Election Ballot

Saturday, May 6, 2023
Election Day
Last Day to Receive Ballot by Mail









The Lovejoy ISD Community News website is intended to facilitate connections and raise awareness of local events, activities, fundraisers and organizations that might interest Lovejoy families.


The information featured on the Community News website is
Lovejoy ISD is not affiliated with the organizations and does not claim to
The Texas Department of State Health Services released new guidance for the 2022-2023 school year regarding Covid-19 and schools. LISD Health and Safety Measures are posted on the District website, linked below.



